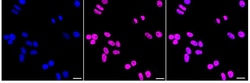
Invitrogen BRG1 Recombinant Rabbit Monoclonal Antibody (24GB2065) 100 &mu;L;

missing translation for 'onlineSavingsMsg'
Learn More
Learn More
Invitrogen™ BRG1 Recombinant Rabbit Monoclonal Antibody (24GB2065)
Rabbit Recombinant Monoclonal Antibody
Brand: Invitrogen™ MA557718
This item is not returnable.
View return policy
Description
BRG1 Recombinant Monoclonal Antibody for Western Blot, ICC/IF, Flow
Brg1 (Brahma-related gene 1) is an ATPase subunit of SWI2/SNF2-like chromatin-remodeling complexes that enable access of regulatory and effector proteins in transcription, DNA repair and DNA replication. Although Brg1-containing complexes are not essential for general cell survival, they participate in transcriptional regulation of several hundred genes including those involved in interferon and stress response, immune cells differentiation, neurogenesis, cell cycle etc. and is absolutely necessary for mouse embryogenesis. Brg1 is also involved in cell growth arrest, senescence and tumour supression.
Specifications
| BRG1 | |
| Recombinant Monoclonal | |
| 0.33 mg/mL | |
| PBS with 50% glycerol and 0.02% sodium azide; pH 7.4 | |
| P51532, Q3TKT4, Q8K1P7 | |
| Smarca4 | |
| A synthesized peptide derived from human BRG1 (aa 210-300). | |
| 100 μL | |
| Primary | |
| Human, Mouse, Rat | |
| Antibody | |
| IgG |
| Flow Cytometry, Western Blot, Immunocytochemistry | |
| 24GB2065 | |
| Unconjugated | |
| Smarca4 | |
| ATP-dependent helicase SMARCA4; b2b508.1Clo; b2b692Clo; BAF190; BAF190A; brahma protein-like 1; BRG1; brg-1; BRG1-associated factor 190A; BRM/SWI2-related gene 1; CSS4; FLJ39786; global transcription activator homologous sequence; homeotic gene regulator; HP1-BP72; hSNF2b; mitotic growth and transcription activator; MRD16; nuclear protein GRB1; protein brahma homolog 1; Protein BRG-1; RTPS2; SMARCA4; SNF2; Snf2b; SNF2beta; SNF2-beta; SNF2L4; SNF2LB; SNF2-like 4; sucrose nonfermenting-like 4; SW1/SNF; SWI/SNF related, matrix associated, actin dependent regulator of chromatin, subfamily a, member 4; SWI/SNF-related matrix-associated actin-dependent regulator of chromatin subfamily A member 4; SWI2; transcription activator BRG1 | |
| Rabbit | |
| Affinity chromatography | |
| RUO | |
| 171379, 20586, 6597 | |
| -20°C | |
| Liquid |
Product Content Correction
Your input is important to us. Please complete this form to provide feedback related to the content on this product.
Product Title
Spot an opportunity for improvement?Share a Content Correction